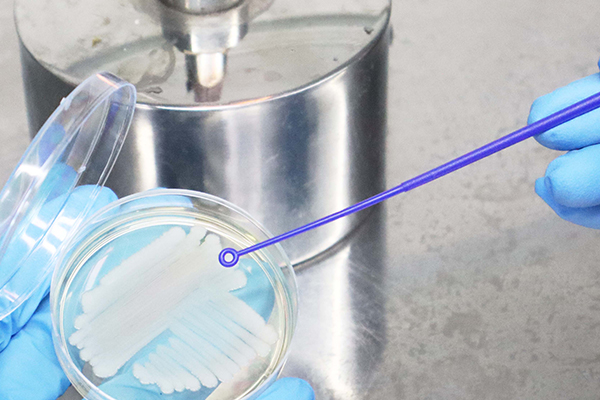

- tianlz@moonbio.com
- No. 11 Kaiyuan Avenue, Huangpu District, Guangzhou City, Guangdong Province, China
xxxxxxxxxxxxxxxxxx
It has four-wheel independent drive, independent suspension, and independent steering chassis, so it has excellent mobility and obstacle surmounting capabilities. Advanced sensor configuration, including 16-line 3D lidar, ultrasonic sensor and anti-fall sensor, can achieve excellent autonomous driving and obstacle avoidance capabilities; 55-centimeter width for flexible passage through narrow and complex indoor environments.
By combining epidemic prevention and disinfection, item distribution and delivery, and exhibition display into one, operating costs are greatly reduced. The modular design of the universal mobile platform allows for easy switching of disinfection modules to other robot functional modules when disinfection functionality is not needed, thus achieving the highest level of operational efficiency。
We have over 320,000 Microbial strains preserved, covering approximately 14,000 species and 10,000 high-value strains. The strains are extracted from the natural environment, animals, plants, food and beverages, etc. We have established one of the world’s largest Fusarium strain resource libraries, with 7,000+ strains covering 200+ species, including 100+ high-value strains.
Based on the commercial requirements of mycoprotein, a proprietary functional prediction and rapid screening technology has been disruptive developed.Over 500 strains can be functionally screened monthly. Efficiently screen natural strains with higher protein content, better amino acid composition, rapid growth and non-toxicity.




We are establishing a large-scale pilot plant for liquid and solid fungi fermentaion and post-treatment equipment. Meanwhile, there are Application Development Room and Physical and chemical testing laboratory, providing solid hardware support for scientific research and innovation.
We have over 50 types of mycoprotein foods and application solutions in the fields of meatballs, sausages, fried foods, snacks and dairy products. Customized fusion and innovation can also be provided to meet personalized needs. Advanced texture technology and enzyme cross-linking are used to create layered meat-like products with chewy texture. Mature encapsulation and controlled-release technology regulates the flavor delivery from substances, enhancing the taste.


Engage in in-depth communication with the customer to understand their requirements, including work scenarios, types of tasks, performance requirements etc.
Design a specialized robot solution that meets their needs, including robot structure, control system, sensor configuration etc.
Produce prototypes according to the design, conduct testing, and optimization.
After testing and optimization, proceed with mass production to ensure product quality and delivery timelines.
Copyright © 2025 MoreMeat (Guangzhou) Biotechnology Co., Ltd. All rights reserved.